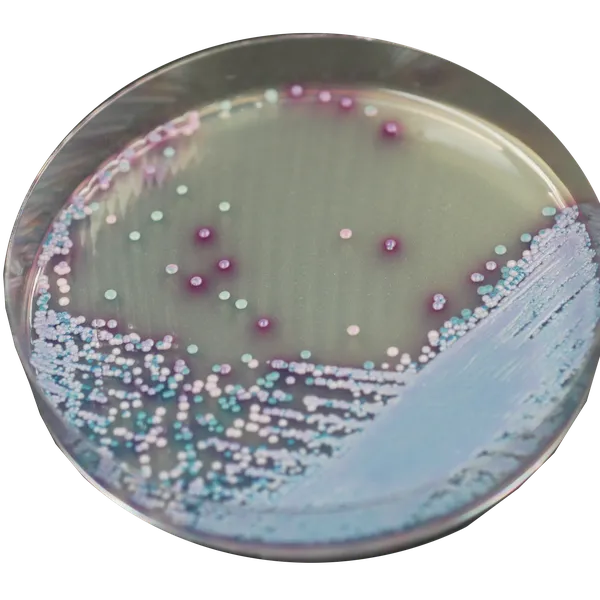
CHROMagar™ Malassezia

Colonies Appearance

Malassezia furfur
large, pale pink and wrinkled

Other Malassezia spp including M. globosa & M. restricta
mostly pink to purple
Performance
Performance
Malassezia is a fungi naturally found on animal skins. On normal healthy skin it does not cause infections, but when the environment of the skin is altered, Malassezia species are able to cause several cutaneous diseases as severe dermatitis or otitis (inflammation of the skin or ears respectively).
Since members of the genus Malassezia share similar morphological and biochemical characteristics, the use of traditional culture media for differentiating them based on phenotypic features is not suitable. CHROMagar™ Malassezia was developed with the goal of facilitating not only their detection, but also to improve an algorithm for the differentiation of the most common species.
(see : Revised Culture-Based System for Identification of Malassezia Species, par Takamasa et al. JCM No-2007)

Composition

Technical Documents
Scientific Publications
2012
Characterization of Malassezia spp. In oral cavity of dog Department of Microbiology and Immunology, Nihon University School of Dentistry at Matsudo, Chiba 271-8587 Japan
📄 Publication2012
Prevalence of Malassezia species in patients with pityriasis versicolor in Rosario, Argentina
📄 Publication2006
Tween 40-based precipitate production observed on modified chromogenic agar and development of biological identification kit for Malassezia species
📄 Publication

Read more